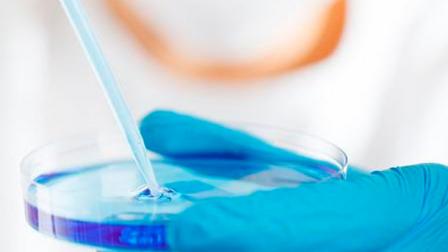

Irán sospecha que Israel envenenó a dos científicos nucleares
Compartir
Actualizada:
13 jun 2022 - 16:06
Irán sospecha que Israel envenenó a dos científicos fallecidos recientemente en el país, según informó este lunes el diario estadounidense The New York Times citando a fuentes anónimas gubernamentales.
Las víctimas eran Ayoub Entezari, un ingeniero aeronáutico que trabajaba en un centro de investigación militar, y Kamran Aghamolaei, un geólogo que según algunos medios trabajaba en una instalación nuclear, aunque esa información no parece totalmente confirmada.
Los hombres enfermaron repentinamente
La muerte de los dos hombres, que enfermaron repentinamente a finales de mayo y terminaron por perder la vida, se suma a otros fallecimientos en extrañas circunstancias de miembros de la Guardia Revolucionaria iraní y de expertos atómicos.
Entezari desarrolló síntomas de una intoxicación alimentaria tras una cena a la que fue invitado y cuyo anfitrión desapareció y está siendo buscado por las autoridades iraníes, según las fuentes del Times.
Mientras, Aghamolaei comenzó a sufrir náuseas y diarrea poco después de volver a Teherán tras un viaje y su estado empeoró hasta que falleció poco después, explica el periódico.
En los últimos años, Irán ha acusado a Israel de llevar a cabo asesinatos contra miembros de sus fuerzas de seguridad y científicos nucleares, además de tratar de sabotear instalaciones iraníes.
Muerte en circustancias poco claras
Además de estos dos casos, este fin de semana murieron en circunstancias poco claras dos miembros de la división aeroespacial de la Guardia Revolucionaria de Irán, según informaron este lunes los medios del país persa.
Uno de los fallecidos es Ali Kamani, miembro de la Unidad Aeroespacial de la ciudad de Khomein, en el centro del país, quien murió durante una misión en un accidente de vehículo, indicó la agencia de noticias Tasnim, vinculada a la Guardia Revolucionaria.
El segundo fallecido es Mohammad Abdous, miembro de la fuerza aeroespacial de la ciudad de Semnan, en el norte del país y donde se encuentra el Centro Espacial Imán Jomeiní.
Las agencias de noticias Tasnim y Fars, cercanas a la Guardia Revolucionaria, señalaron a los muertos como "mártires", término usado en Irán para describir a los fallecidos en acto de servicio o asesinados por "el enemigo".
Estos casos se suman al fallecimiento a principios de este mes del coronel de la fuerza de élite Quds Ali Esmaílzadeh "en un accidente en su residencia", en la ciudad de Karaj, situada en el oeste de Teherán.
Mire también
Además, a mediados de mayo el coronel de la Guardia Revolucionaria de Irán Sayyad Khodaei fue asesinado por dos hombres de cinco disparos en la puerta de su casa en el centro de Teherán, una muerte de la que Irán ya acusó a Israel.
Estas muertes se están produciendo cuando las negociaciones para salvar el pacto nuclear de 2015 se encuentran paralizadas desde mediados de marzo. EFE
Compartir